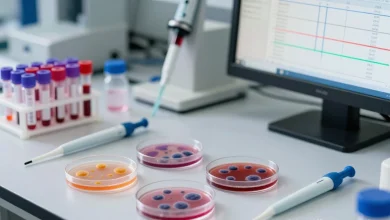
ارزیابی پنج ساله الگوهای حساسیت ضدمیکروبی باکتریهای عامل عفونتهای خونی

- بررسی اثربخشی فتودینامیک و فتوترمال بر تشکیل بیوفیلم استرپتوکوکوس موتانس: یک مطالعه آزمایشگاهی
- بررسی فوتوسنسیتایزرهای مختلف برای بهینهسازی حذف فرمهای پلانکتونیک و بیوفیلم انتروکوکوس فکالیس از کانال ریشه آلوده در طی فتودینامیک درمانی ضد میکروبی
- گستردگی وسیع آسینتوباکتر بومانی مقاوم به کارباپنم در بیماران سوختگی در ایران
- ارزیابی پنجساله الگوهای مقاومت باکتریها در عفونتهای خون در ایران
- تشخیص عفونت هلیکوباکتر پیلوری با آزمایشهای تهاجمی و غیرتهاجمی
سلامتی و زیبایی
-
مقالات
پیشگیری سرطان از تصمیمهای کوچک شما شروع میشود | سبک زندگی سالم
آیا واقعاً سرطان فقط به ژنتیک ربط دارد؟ اگر ژنها همهچیز را تعیین میکردند، چرا افراد با شرایط ژنتیکی مشابه،…
بیشتر بخوانید » -
سلامت و زیبایی
پوست خشک صورت را چگونه درمان کنیم؟
خشکی پوست صورت یکی از مشکلاتی است که بسیاری از افراد در مقاطع مختلف سال بهویژه در فصل زمستان با…
بیشتر بخوانید » -
سلامت و زیبایی
فیشیال صورت در خانه چگونه است؟
داشتن پوستی سالم، شفاف و درخشان آرزوی بسیاری از افراد است. پوست صورت بیشترین تأثیر را در زیبایی و اعتمادبهنفس…
بیشتر بخوانید »
صنایع غذایی
-
صنایع غذایی
چگونه خط تولید کشمش صنعتی راه اندازی کنیم؟
کشمش از جمله فرآوردههای خوشمزه و پرطرفدار انگور است که علاوه بر طعم دلپذیر، سرشار از ارزش غذایی است. این…
بیشتر بخوانید » -
صنایع غذایی
خط تولید صنایع غذایی | راه اندازی خط تولید انواع ادویه + حبوبات و …
خط تولید صنایع غذایی به مجموعهای از فرآیندها، تجهیزات و فناوریهایی گفته میشود که مواد خام کشاورزی یا دامی را…
بیشتر بخوانید »